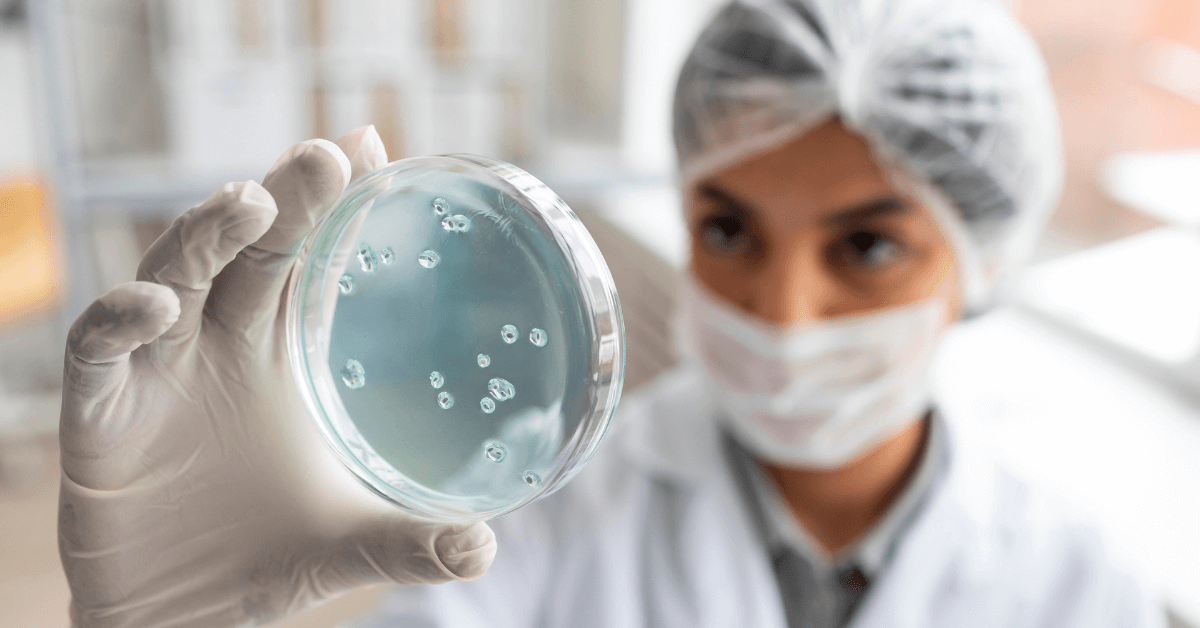

Da li u trudnoći možete da obolite od streptokokne infekcije?
Naravno da niko ne želi da muči muku sa ovom bakterijskom infekcijom, naročito ne trudnice koje tokom hladnih meseci dodatno treba da paze na svoje zdravlje. Olakšavajuća okolnost za svaku trudnicu je da ne postoji povećani rizik za oboljenje od bakterije streptokok tokom trudnoće, ali svaka žena, bez obzira na trudnoću, može biti podložna ovoj bakterijskoj infekciji.
Znaci i simptomi streptokoknog grla
Prvi znaci streptokokong grla pojaviće se iznenada, a period inikubacije traje dva do pet dana. To znači da se prvi simptomi neće pojaviti odmah, već tek nakon nekoliko dana nakon što ste bili u direktnom kontaktu sa osobom koja je bolesna.

Foto: Freepik
- Otečeni i osetljivi limfni čvorovi na vratu
- Groznica
- Glavobolje
- Gubitak apetita
- Osip
- Povećan umor
Šta je streptokok grupe B?
Streptokok grupe B nije isto što i infekcija streptokoknog grla
U odnosu na streptokokno grlo, streptokok grupe B je potpuno drugačija vrsta bakterijske infekcije. Streptokok grupe B je vrsta infekcije koja se nalazi u vaginalnoj ili rektalnoj oblasti, a koju majka može preneti na svoju bebu tokom porođaja. Nije u pitanju bilo kakva vrsta polno prenosive bolesti, a većina trudnica se testira između 35. i 37. nedelje trudnoće na prisustvo ove infekcije.
Koji su uzroci streptokoknog grla?
Glavni uzročnik streptokoknog grla je bakterija Streptococcus grupe A (GAS) ili Streptococcus piogenes.
Foto: Freepik
Kako da se zaštite tokom trudnoće
“Poljubac u obraz” se nikako ne savetuje
Savetuje se da tokom poodmakle trudnoće, a naročito tokom zimskih meseci kao i tokom ranog proleća, izbegavate „poljubac u obraz” kao savremeni način pozdrava kao i preveliku gužvu u zagušljivim prostorijama.
Smanjite simptome upale kod kuće
Kako biste smanjile simptome koji vam sve više zadaju poteškoće, možete potražiti određene biljne čajeve bez kofeina poput čaja od kamilice ili čaja od limuna sa cimetom, koji mogu delovati kao prirodni lekovi kako bi se smanjio bol u grlu.
Možete takođe probati:
- Ispiranje grla slanom vodom. Sipajte jednu četvrtinu kašičice soli u 200ml vode i ispirajte grlo nekoliko sekundi, a zatim ispljunite.
- Konzumirajte tople napitke u koje možete dodati malo meda, limuna ili cimeta.
- Izbegavajte sokove od citrusnog voća, poput naranDže ili ananasa, jer oni mogu iritirati grlo.
.png)
Foto: Freepik
Obavestite lekara o svojim simptomima
Ukoliko imate upalu grla ne znači nužno da imate i streptokoknu infekciju. Alergije i druge infekcije mogu lako izazvati upalu i iritaciju u grlu. Ako imate upalu grla sa temperaturom, trebalo bi da se obratite svom lekaru. Vaš lekar će vam dati „strep test„ (kultura prikupljena brisom na krajnicima) da utvrdi da li je u pitanju streptokokna infekcija.
Pročitajte kako lečiti prehladu u trudnoći


























































































































































Komentari (0)